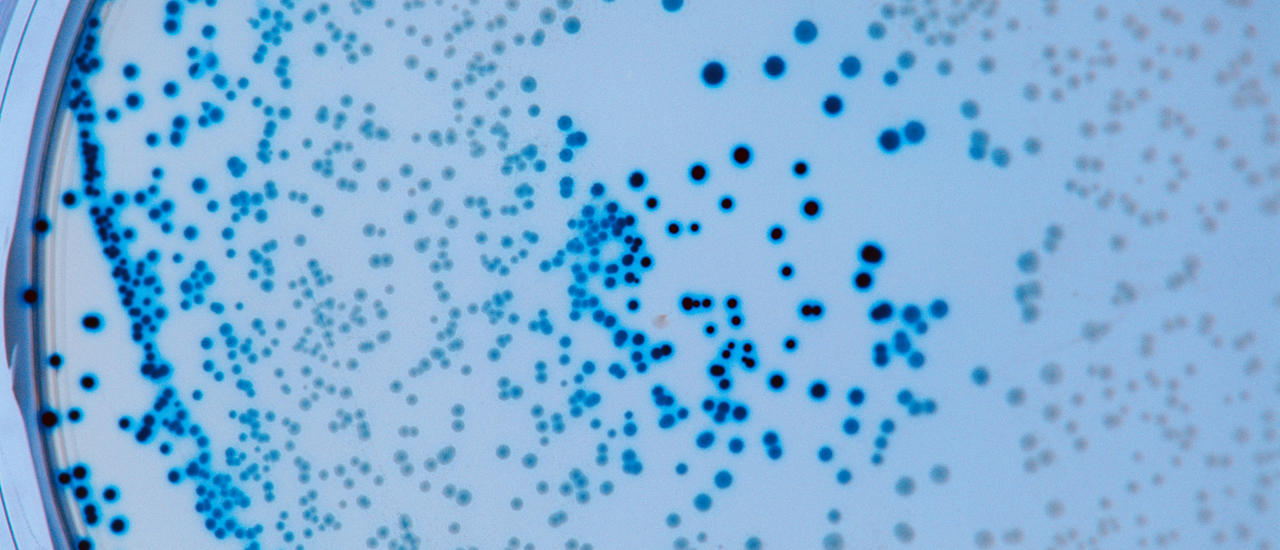

Modern Marvels Corrosion And Decomposition Worksheet Answers
Here are some of the images for Modern Marvels Corrosion And Decomposition Worksheet Answers that we found in our website database.

Modern Marvels Worksheet Answers Free Worksheets Samples

Unveiling the Secrets: Modern Marvels Corrosion and Decomposition

Unveiling the Secrets: Modern Marvels Corrosion and Decomposition

Unveiling the Secrets: Modern Marvels Corrosion and Decomposition

Modern Marvels Corrosion And Decomposition Worksheet Answers

Modern marvels TPT Worksheets Library

Modern Marvels Assignment PDF Transport Aviation Worksheets Library

Modern Marvels Worksheet Answers Printable Word Searches

Modern Marvels Renewable Resources Worksheet Answers winifreg

Modern Marvels Corrosion Decomposition : r/sciencemovies

Modern Marvels Worksheet Answers

Modern Marvels Worksheet Answers

Modern Marvels Renewable Energy Worksheet Answers Printable Word Searches

Modern Marvels Reneble Energy Worksheet Answers db excel com

Modern Marvels Renewable Energy Worksheet Answers Printable Word Searches

Free modern marvels worksheet Download Free modern marvels worksheet

Free modern marvels worksheet Download Free modern marvels worksheet

Modern Marvels : Corrosion and Decomposition (2008) Synopsis

Modern Marvels Cheese Worksheet Answers

Modern Marvels Acids Worksheet Printable And Enjoyable Learning

Modern Marvels Acid Worksheet Printable Word Searches

Modern Marvels Forensic Science Worksheet Answer Key

Modern Marvels Forensic Science Worksheet Answer Key

Modern Marvels Worksheet Answer Key Printable Word Searches

Modern Marvels Paint Episode Worksheet by Amanda #39 s Agricultural

Modern Marvels Dirt Episode Worksheet by Amanda #39 s Agricultural

Modern Marvels Cotton Video Worksheet by Amanda #39 s Agricultural

Modern Marvels Cheese Video Worksheet by Amanda #39 s Agricultural

Modern Marvels Corrosions and Decomposition docx Name Hour Modern

Amazon com: Modern Marvels:corrosion/decmp : Movies TV

Modern Marvels Corrosions and Decomposition 1 docx Name Kaden

Prime Factor Decomposition Using Factor Trees Worksheet

Modern Marvels Worksheet Answer Key Modern Marvels Worksheets

Modern Marvels Milk episode worksheet by Amanda #39 s Agricultural

Modern Marvels Milk episode worksheet by Amanda #39 s Agricultural

Modern Marvels Eggs episode worksheet by Amanda #39 s Agricultural

Modern Marvels:corrosion/decmp Walmart Canada

Modern Marvels Wood episode worksheet with answer key TPT

Using Prime Factor Decomposition Worksheet Printable PDF Year 8 and

Using Prime Factor Decomposition Worksheet Printable PDF Year 8 and

Modern Marvels Welding Video Worksheet Answer Key Printable Word Searches

quot Modern Marvels: Candy quot Video Worksheet w/ Answer Key by Hanna Lewis

Area of Polygon by Decomposition Worksheets (printable online answers

Using Prime Factor Decomposition Worksheet Printable PDF Year 8 and

SOLVED: Science of Materials Question 1 The following questions

Modern Marvels Heavy Metals Viewing Guide by Carey Munoz TpT

Understanding Corrosion and Decomposition in Modern Course Hero
Western Australia Microbial Marvels: unveiling the hidden world of

Panama Canal Modern Marvels questions docx Name: Date: Period: Modern

Using Prime Decomposition to Find HCF and LCM (B) Worksheet Fun and

Exploring the Seven Industrial Wonders of the World: Panama Canal

Corrosion Nippon Paint Automotive Refinish

Numbers Decomposition Worksheet

Modern Marvels Panama Canal Video Guide (w/ Key) TPT

Modern Marvels Corrosion Decomposition YouTube

Gender Prediction Chinese Calendar prntbl concejomunicipaldechinu gov co

Integrations WhatsApp Business Zoho Payroll Help

Steel Salvation: The Art of Nanomagic for Unstoppable Anti Corrosion

Prime Factor Decomposition Using Factor Trees Worksheet Printable PDF

9 Free Decomposing Numbers Kindergarten Worksheet